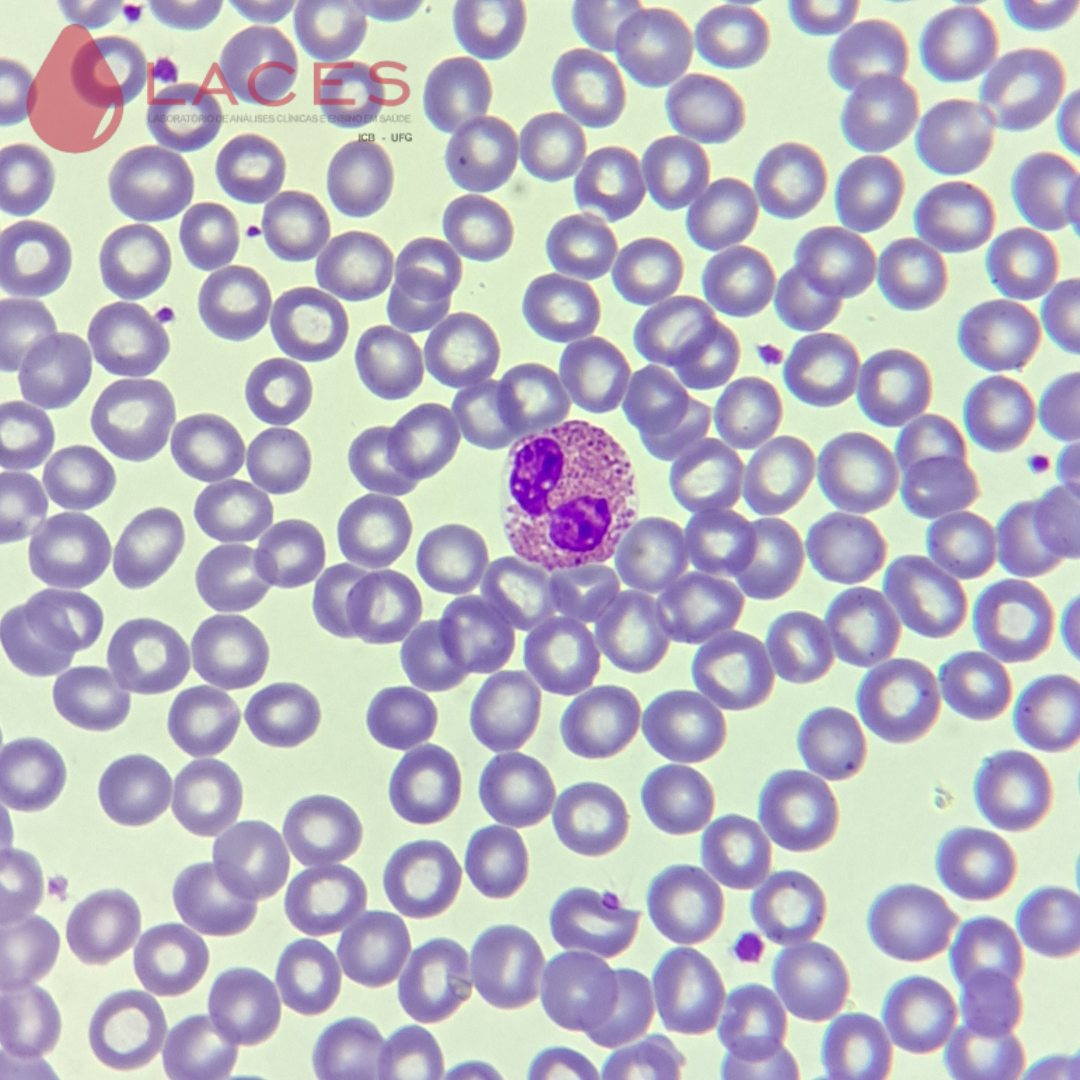
Eosinófilo (formato do núcleo característico bilobulado com grânulos eosinofílicos no citoplasma). Hemácias normocíticas e normocrômicas.

Segmentado Eosinófilo
         Atualizada em 06/10/25 09:49
    
  
  Geralmente possuem dois lóbulos e grânulos alaranjados e grosseiros no citoplasma. Aumentam muito durante processos alérgicos e doenças parasitárias, tendo sua porcentagem normal no sangue periférico de 2 a 4%. Exibem granulações maiores que os neutrófilos e de cor alaranjada ou rósea.

Figura 1: Eosinófilo.

Figura 2: Eosinófilo.
_(seta)__Neutr%C3%B3filo_bastonete(possui_chanfradura_e_est%C3%A1_em_transi%C3%A7%C3%A3o_para_segmentado)_(seta_tracejada).jpg)
Figura 3: Eosinófilo(presença de 3 lóbulos) (seta); Neutrófilo bastonete(possui chanfradura e está em transição para segmentado) (seta tracejada).

Figura 4: Eosinófilo com 3 lóbulos.
 
Figura 5: Eosinófilos (setas) e neutrófilo (seta tracejada).
Figura 6: Eosinófilo (formato do núcleo característico bilobulado com grânulos eosinofílicos no citoplasma). Hemácias normocíticas e normocrômicas.
    